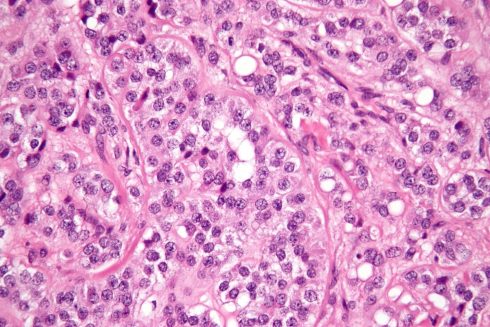
تومورهای سلول سرتولی (Sertoli cell tumors)

مقدمهای بر سرطان بیضه
سرطان زمانی شروع میشود که سلولها شروع به رشد خارج از کنترل میکنند. سلولها تقریباً در هر قسمت از بدن میتوانند تبدیل به سرطان شوند و به سایر قسمتهای بدن گسترش یابند.
سرطانی که از بیضه شروع میشود، سرطان بیضه (testicular cancer) نامیده میشود. برای درک این سرطان، دانستن اطلاعاتی در رابطه با ساختار و عملکرد طبیعی بیضهها به ما کمک میکند.
بیضهها (testicles) چیستند؟
بیضهها (همچنین testes نامیده میشود؛ بیضه منفرد testis نامیده میشود) بخشی از دستگاه تناسلی مرد است. معمولاً این دو اندام به اندازه کمی کوچکتر از یک توپ گلف در مردان بالغ هستند. آنها درون کیسه ای از پوست به نام کیسه بیضه (scrotum) نگهداری میشوند. کیسه بیضه زیر قاعده آلت تناسلی آویزان است.

بیضهها 2 وظیفه اصلی دارند:
- هورمونهای مردانه (آندروژنها) مانند تستوسترون (testosterone) را میسازند.
- آنها اسپرم (سلولهای مردانه مورد نیاز برای بارور کردن سلول تخمک ماده برای شروع بارداری) میسازند.
سلولهای اسپرم در لولههای نخ مانند در داخل بیضهها به نام لولههای اسپرم ساز (seminiferous tubules) ساخته میشوند. سپس این سلولها در یک لوله کوچک پیچیده در پشت هر بیضه به نام اپیدیدیم (epididymis) ذخیره میشوند. اسپرمها در این مکان بالغ میشوند.
در طول انزال، سلولهای اسپرم از اپیدیدیم از طریق مجرای دفران به وزیکولهای منی منتقل میشوند. در آن جا، آنها با مایعات ساخته شده توسط وزیکولها، غده پروستات و سایر غدد مخلوط میشوند و منی را تشکیل میدهند. این مایع سپس وارد مجرای ادرار میشود، لوله ای در مرکز آلت تناسلی که از طریق آن ادرار و منی از بدن خارج میشوند.
انواع سرطان بیضه
بیضهها از انواع مختلفی از سلولها تشکیل شده اند که هر کدام میتوانند به یک یا چند نوع سرطان تبدیل شوند. دانستن نوع سلولی که سرطان در آن شروع شده است و نوع سرطان آن مهم است زیرا این انواع در نحوه درمان و پیش آگهی (چشم انداز) متفاوت هستند.
پزشکان با نگاه کردن به سلولها و بررسی آنها در زیر میکروسکوپ میتوانند تشخیص دهند که چه نوع سرطان بیضهای را دارید.
تومورهای سلول زایا (Germ cell tumors)
بیش از 90 درصد سرطانهای بیضه در سلولهایی به نام سلولهای زایا (germ cells) شروع میشود. اینها سلولهایی هستند که اسپرم را میسازند. انواع اصلی تومورهای سلول زایا (GCTs یا germ cell tumors) در بیضهها سمینوما (seminomas) و غیر سمینوما (non-seminomas) هستند.
این دو نوع تقریباً به یک اندازه رخ میدهند. بسیاری از سرطانهای بیضه حاوی سلولهای سمینوما و غیر سمینوما هستند. این تومورهای سلول زایای مختلط به عنوان غیر سمینوما در نظر گرفته میشوند زیرا مانند غیر سمینوما رشد و گسترش مییابند.
سمینومها (Seminomas)

سمینوماها نسبت به غیر سمینوما تمایل به رشد و انتشار کندتری دارند. 2 زیر نوع اصلی این تومورها سمینومای کلاسیک (یا تیپیک) و سمینومای اسپرماتوسیتی هستند.
- سمینوم کلاسیک (Classical seminoma): بیش از 95 درصد سمینوماها کلاسیک هستند. این نوع معمولا در مردان بین 25 تا 45 سال رخ میدهد.
- سمینوم اسپرماتوسیتی (Spermatocytic seminoma): این نوع نادر از سمینوما در مردان مسن ایجاد میشود. (متوسط سن حدود 65 سال است.) تومورهای اسپرماتوسیتی نسبت به سمینومای کلاسیک تمایل به رشد آهسته تری دارند و کمتر به سایر قسمتهای بدن گسترش مییابند.
برخی از سمینومها میتوانند سطح پروتئینی به نام گنادوتروپین جفتی انسانی (human chorionic gonadotropin یا HCG) را در خون افزایش دهند. HCG را میتوان با یک آزمایش خون ساده بررسی کرد و به عنوان نشانگر تومور برای انواع خاصی از سرطان بیضه در نظر گرفته میشود. میتوان از آن برای تشخیص و بررسی نحوه پاسخ بیمار به درمان استفاده کرد.
غیر سمینوما (Non-seminomas)

این نوع تومورهای سلول زایا معمولاً در مردان بین اواخر نوجوانی و اوایل 30 سالگی رخ میدهند. 4 نوع اصلی تومورهای غیر سمینوما عبارتند از: کارسینوم جنینی، کارسینوم کیسه زرده، کوریوکارسینوما و تراتوم. بیشتر تومورها ترکیبی از انواع مختلف هستند (گاهی اوقات با سلولهای سمینوما نیز همراه هستند) اما این موضوع روند درمان اکثر سرطانهای غیر سمینوما را تغییر نمیدهد.
کارسینوم جنینی (Embryonal carcinoma): این سلولها در حدود 40 درصد از تومورهای بیضه یافت میشوند اما کارسینوم جنینی خالص تنها در 3 تا 4 درصد مواقع رخ میدهد. هنگامی که این تومورها در زیر میکروسکوپ دیده میشوند، میتوانند مانند بافتهای جنینی بسیار اولیه به نظر برسند. این نوع غیر سمینوما تمایل به رشد سریع دارد و در خارج از بیضه پخش میشود.
کارسینوم جنینی میتواند سطوح خونی پروتئین نشانگر تومور به نام آلفا فتوپروتئین (alpha-fetoprotein یا AFP) و همچنین گنادوتروپین جفتی انسانی (HCG) را افزایش دهد.
کارسینوم کیسه زرده (Yolk sac carcinoma): این تومورها به این دلیل اینگونه نامیده میشوند که سلولهای آنها شبیه کیسه زرده جنین اولیه انسان است. نامهای دیگر این سرطان عبارتند از: تومور کیسه زرده (yolk sac tumor)، تومور سینوس اندودرم (endodermal sinus tumor)، کارسینوم جنینی نوزادی (infantile embryonal carcinoma) یا ارکیدوبلاستوم (orchidoblastoma).
این نوع شایع ترین شکل سرطان بیضه در کودکان (به ویژه در نوزادان) است اما کارسینوم کیسه زرده خالص (تومورهایی که انواع دیگری از سلولهای غیر سمینوما در آنها وجود ندارد) در بزرگسالان نادر است. هنگامی که این نوع در کودکان رخ میدهد، این تومورها معمولاً با موفقیت درمان میشوند. اما هنگامی که در بزرگسالان رخ میدهد بیشتر نگران کننده هستند، به خصوص اگر خالص باشند. کارسینوم کیسه زرده به شیمی درمانی بسیار خوب پاسخ میدهد، حتی اگر گسترش یافته باشد.
این نوع تومور تقریباً همیشه سطح AFP (آلفا فتوپروتئین) خون را افزایش میدهد.
کوریوکارسینوما (choriocarcinoma): این یک نوع سرطان بیضه، نوعی بسیار نادر و با رشد سریع در بزرگسالان است. کوریوکارسینوم خالص احتمالاً به سرعت به سایر قسمتهای بدن از جمله ریهها، استخوانها و مغز گسترش مییابد.
بیشتر اوقات، سلولهای کوریوکارسینوما با انواع دیگر سلولهای غیر سمینوما در یک تومور سلول زایای مختلط دیده میشوند. این تومورهای مختلط نسبت به کوریوکارسینومهای خالص چشم انداز بهتری دارند، اگرچه وجود کوریوکارسینوما همیشه یک یافته نگران کننده است.
این نوع تومور باعث افزایش سطح HCG (گنادوتروپین جفتی انسان) در خون میشود.
تراتوم (Teratoma): تراتومها تومورهای سلول زایا با مناطقی هستند که در زیر میکروسکوپ شبیه هر یک از 3 لایه یک جنین در حال رشد میباشند: اندودرم (endoderm، داخلی ترین لایه)، مزودرم (mesoderm، لایه میانی) و اکتودرم (ectoderm، لایه بیرونی). تراتوم خالص بیضه نادر است و سطح AFP (آلفا فتوپروتئین) یا HCG (گنادوتروپین جفتی انسان) را افزایش نمیدهد. اغلب تراتومها به عنوان بخشی از تومورهای سلول زایای مختلط دیده میشوند.
3 نوع اصلی تراتوم وجود دارد:
- تراتومهای بالغ (Mature teratomas) تومورهایی هستند که توسط سلولهای بسیار شبیه سلولهای بافتهای بالغ تشکیل میشوند. به ندرت پخش میشوند. آنها معمولاً با جراحی قابل درمان هستند اما برخی از آنها پس از درمان عود میکنند.
- تراتومهای نابالغ (Immature teratomas) سرطانهایی هستند که کمتر توسعه یافته اند و سلولهایی شبیه سلولهای جنین اولیه دارند. این نوع بیشتر از یک تراتوم بالغ به بافتهای مجاور رشد میکند (تهاجمی است)، در خارج از بیضه پخش میشود (متاستاز میکند) و سالها پس از درمان عود میکند.
- تراتوم با بدخیمی نوع سوماتیک (Teratomas with somatic type malignancy) بسیار نادر است. این سرطانها دارای مناطقی هستند که شبیه تراتومهای بالغ است اما دارای مناطق دیگری هستند که سلولها به نوعی سرطان تبدیل شده اند که به طور معمول در خارج از بیضه ایجاد میشود (مانند سارکوم، آدنوکارسینوم یا حتی لوسمی).
کارسینوم درجا یا در محل بیضه (Carcinoma in situ of the testicle)
سرطان سلول زایای بیضه میتواند به عنوان یک شکل غیر تهاجمی بیماری به نام کارسینوم درجا (carcinoma in situ یا CIS) یا نئوپلازی سلول زایای داخل لوله ای (intratubular germ cell neoplasia) شروع شود. در CIS بیضه، سلولها در زیر میکروسکوپ غیر طبیعی به نظر میرسند اما هنوز در خارج از دیواره لولههای اسپرم ساز (محل تشکیل سلولهای اسپرم) پخش نشده اند. کارسینوم درجا همیشه به سرطان مهاجم پیشرفت نمیکند.
پیدا کردن CIS قبل از تبدیل شدن به یک سرطان تهاجمی دشوار است زیرا معمولاً علائم یا توده ای را ایجاد نمیکند که شما یا پزشک آن را احساس کنید. تنها راه برای تشخیص CIS بیضه، بیوپسی (نمونه برداری) است. (این روشی برای بیرون آوردن یک بافت کوچک است تا بتوان آن را زیر میکروسکوپ بررسی کرد).
کارشناسان در مورد بهترین روش درمان برای CIS توافق ندارند. از آن جایی که CIS همیشه به یک سرطان مهاجم تبدیل نمیشود، بسیاری از پزشکان در ایالات متحده مشاهده (بررسی هوشیارانه) را بهترین گزینه درمانی میدانند.
هنگامی که CIS بیضه تهاجمی میشود، سلولهای آن دیگر فقط در لولههای اسپرم ساز نیستند، بلکه به ساختارهای دیگر بیضه تبدیل شده اند. این سلولهای سرطانی میتوانند از طریق رگهای لنفاوی (lymphatic vessels، لولههای پر از مایع ریز که گرههای لنفاوی را به هم متصل میکنند) به غدد لنفاوی (lymph nodes، مجموعههای کوچک و لوبیایی شکل از گلبولهای سفید خون) یا از طریق خون به سایر قسمتهای بدن گسترش یابند.
تومورهای استرومایی (Stromal tumors)
تومورها همچنین میتوانند در بافتهای حمایت کننده و تولید کننده هورمون یا استرومای بیضهها شروع شوند. این تومورها به عنوان تومورهای استرومایی گناد (gonadal stromal tumors) شناخته میشوند. آنها کمتر از 5 درصد از تومورهای بیضه بزرگسالان را تشکیل میدهند اما تا 20 درصد از تومورهای بیضه دوران کودکی را شامل میشوند. انواع اصلی آنها تومورهای سلول لیدیگ (Leydig cell tumors) و تومورهای سلولی سرتولی (Sertoli cell tumors) هستند.
تومورهای سلول لیدیگ (Leydig cell tumors)
این تومورها از سلولهای لیدیگ در بیضه شروع میشوند که به طور معمول هورمونهای جنسی مردانه (آندروژنهایی مانند تستوسترون) را میسازند. تومورهای سلول لیدیگ میتوانند هم در بزرگسالان و هم در کودکان ایجاد شوند. این تومورها اغلب آندروژن (androgens، هورمونهای مردانه) میسازند اما گاهی اوقات استروژن (estrogens، هورمونهای جنسی زنانه) نیز تولید میکنند.
بیشتر تومورهای سلول لیدیگ سرطانی (بدخیم) نیستند. آنها به ندرت فراتر از بیضه گسترش مییابند و اغلب با جراحی قابل درمان هستند. با این حال، تعداد کمی از تومورهای سلول لیدیگ به سایر قسمتهای بدن گسترش مییابند. اینها معمولاً چشمانداز ضعیفی دارند زیرا معمولاً به شیمی درمانی یا پرتو درمانی به خوبی پاسخ نمیدهند.
تومورهای سلول سرتولی (Sertoli cell tumors)
این تومورها از سلولهای سرتولی طبیعی شروع میشوند که از سلولهای زایا سازنده اسپرم حمایت و تغذیه میکنند. مانند تومورهای سلول لیدیگ، این تومورها معمولاً خوش خیم هستند اما اگر گسترش پیدا کنند، معمولاً به شیمی درمانی یا پرتو درمانی پاسخ خوبی نمیدهند.
سرطانهای ثانویه بیضه (Secondary testicular cancers)
سرطانهایی که از اندام دیگری شروع میشوند و سپس به بیضه گسترش مییابند (متاستاز میکنند) سرطان بیضه ثانویه نامیده میشود. اینها سرطانهای بیضه واقعی نیستند. به معنای اینکه آنها از بیضهها شروع نمیشوند. آنها بر اساس جایی که در آن شروع شده اند، نامگذاری و درمان میشوند.
لنفوم (Lymphoma) شایع ترین سرطان ثانویه بیضه است. لنفوم بیضه در مردان بالای 50 سال بیشتر از تومورهای اولیه بیضه است. چشم انداز به نوع و مرحله لنفوم بستگی دارد. روند درمان معمول شامل برداشتن با جراحی و به دنبال آن پرتو درمانی و یا شیمی درمانی است.
در پسران مبتلا به لوسمی حاد (acute leukemia)، سلولهای لوسمی گاهی اوقات میتوانند توموری را در بیضه ایجاد کنند.
همراه با شیمی درمانی برای درمان لوسمی، این سرطان ممکن است نیاز به درمان با پرتو درمانی یا جراحی برای برداشتن بیضه داشته باشد.
سرطانهای پروستات، ریه، پوست (ملانوم)، کلیه و سایر اندامها نیز میتوانند به بیضهها سرایت کنند. پیش آگهی این سرطانها ضعیف است زیرا این سرطانها معمولاً به طور گسترده به سایر اندامها نیز گسترش یافته اند. روند درمان بستگی به نوع خاص سرطان دارد.
آمار کلیدی برای سرطان بیضه
برآوردهای انجمن سرطان آمریکا برای سرطان بیضه در ایالات متحده برای سال 2022 عبارتند از:
- حدود 9910 مورد جدید سرطان بیضه
- حدود 460 مرگ ناشی از سرطان بیضه
میزان بروز سرطان بیضه برای چندین دهه در ایالات متحده و بسیاری از کشورهای دیگر افزایش یافته است. این افزایش بیشتر در سمینومها است. کارشناسان نتوانسته اند دلایلی برای این موضوع بیابند. اخیراً سرعت این افزایش کاهش یافته است.
سرطان بیضه شایع نیست: از هر 250 مرد، 1 نفر در طول زندگی خود به سرطان بیضه مبتلا میشود.
میانگین سنی در زمان تشخیص سرطان بیضه حدود 33 سال است. این بیماری عمدتاً در مردان جوان و میانسال ایجاد میشود اما حدود 6 درصد موارد در کودکان و نوجوانان و حدود 8 درصد در مردان بالای سن 55 سال رخ میدهد.
از آن جایی که سرطان بیضه معمولاً میتواند با موفقیت درمان شود، خطر مرگ در طول زندگی مرد در اثر این سرطان بسیار کم است: حدود 1 در 5000. اگر میخواهید در مورد آمار بقا بیشتر بدانید، به مبحث نرخ بقای سرطان بیضه در ادامه مراجعه کنید.
علائم و نشانههای سرطان بیضه
بسیاری از این علائم به احتمال زیاد ناشی از وجود چیزی غیر از سرطان بیضه است. تعدادی از شرایط غیر سرطانی، مانند آسیب یا التهاب بیضه، میتواند علائمی مانند سرطان بیضه را ایجاد کند. التهاب بیضه (معروف به اورکیت یا orchitis) و التهاب اپیدیدیم (اپیدیدیمیت یا epididymitis) میتواند باعث تورم و درد بیضه شود. هر دوی اینها همچنین میتواند ناشی از عفونتهای ویروسی یا باکتریایی باشد.
برخی از مردان مبتلا به سرطان بیضه اصلاً علائمی ندارند و سرطان آنها در طی آزمایشات پزشکی برای بررسی سایر شرایط مشخص میشود. به عنوان مثال، گاهی اوقات آزمایشهای تصویر برداری انجام شده برای یافتن علت ناباروری میتواند سرطان کوچک بیضه را نشان دهد.
اما اگر هر یک از این علائم یا نشانهها را دارید، فوراً به پزشک خود مراجعه کنید.
وجود توده یا تورم در بیضه
اغلب اولین علامت سرطان بیضه وجود توده روی بیضه است یا بیضه متورم یا بزرگتر میشود. (این موضوع طبیعی است که یک بیضه کمی بزرگتر از دیگری باشد و یکی پایین تر از دیگری و آویزان باشد.) برخی از تومورهای بیضه ممکن است باعث درد شوند اما در بیشتر مواقع اینطور نیست. مردان مبتلا به سرطان بیضه همچنین میتوانند احساس سنگینی یا درد در قسمت تحتانی شکم (belly) یا کیسه بیضه داشته باشند.
رشد یا درد سینه
در موارد نادر، تومورهای سلول زایا میتوانند باعث رشد یا درد سینه شوند. این امر به این دلیل اتفاق میافتد که انواع خاصی از تومورهای سلول زایا سطوح بالایی از هورمونی به نام گنادوتروپین جفتی انسانی (HCG) ترشح میکنند که رشد سینه را تحریک میکند.
برخی از تومورهای سلول لیدیگ میتوانند استروژن (هورمونهای جنسی زنانه) بسازند که میتواند باعث رشد سینه یا کاهش میل جنسی شود.
بلوغ زودرس در پسران
برخی از تومورهای سلول لیدیگ میتوانند آندروژن (هورمونهای جنسی مردانه) بسازند. تومورهای تولید کننده آندروژن ممکن است هیچ علامتی در مردان ایجاد نکنند اما در پسران میتوانند علائم بلوغ غیر طبیعی را در سنین پایین ایجاد کنند، مانند عمیق شدن صدا و رشد موهای صورت و بدن.
علائم سرطان پیشرفته بیضه
حتی اگر سرطان بیضه به سایر قسمتهای بدن گسترش یافته باشد، بسیاری از مردان ممکن است فوراً علائمی نداشته باشند. اما برخی از مردان ممکن است برخی از موارد زیر را داشته باشند:
- کمردرد، ناشی از گسترش سرطان به غدد لنفاوی (مجموعه سلولهای ایمنی به اندازه لوبیا) در پشت شکم.
- تنگی نفس، درد قفسه سینه یا سرفه (حتی سرفه خونی) ممکن است از گسترش سرطان در ریهها ایجاد شود.
- درد شکم یا به دلیل بزرگ شدن غدد لنفاوی یا به دلیل گسترش سرطان به کبد.
- سردرد یا گیجی، ناشی از گسترش سرطان در مغز.
چه چیزی باعث سرطان بیضه میشود؟
علت دقیق اکثر سرطانهای بیضه مشخص نیست اما دانشمندان دریافته اند که این بیماری با تعدادی از شرایط و عارضههای دیگر مرتبط است. تحقیقات زیادی برای کسب اطلاعات بیشتر در مورد علل آن انجام میشود.
محققان میآموزند که چگونه تغییرات خاصی در DNA سلول میتواند باعث سرطانی شدن سلول شود. DNA ماده شیمیایی در هر یک از سلولهای ما است که ژنهای ما را میسازد. ژنها به سلولهای ما میگویند که چگونه کار کنند. آنها در کروموزومها بسته بندی میشوند که رشتههای طولانی DNA در هر سلول هستند.
اکثر سلولهای بدن دارای 2 مجموعه 23 کروموزومی هستند (یک مجموعه کروموزوم از هر والدین میآید) اما هر سلول اسپرم یا تخمک فقط 23 کروموزوم دارد (یک مجموعه). هنگامی که اسپرم و تخمک با هم ترکیب میشوند، جنین به دست آمده دارای تعداد طبیعی کروموزوم در هر سلول است که نیمی از آن از هر یک از والدین است. ما معمولا شبیه والدین خود هستیم زیرا آنها منبع DNA ما هستند. اما DNA بر چیزی بیشتر از ظاهر ما تأثیر میگذارد.
برخی از ژنها زمان رشد سلولهای ما، تقسیم به سلولهای جدید و مرگ را کنترل میکنند.
ژنهای خاصی که به رشد و تقسیم سلولها کمک میکنند، انکوژن (oncogenes) نامیده میشوند.
سایر مواردی که تقسیم سلولی را کند میکنند یا سلولها را در زمان مناسب میکشند، ژنهای سرکوب کننده تومور (tumor suppressor genes) نامیده میشوند.
سرطانها میتوانند ناشی از تغییرات کروموزومهایی باشند که انکوژنها را فعال میکنند یا ژنهای سرکوب کننده تومور را خاموش میکنند.
اکثر سلولهای سرطانی بیضه دارای نسخههای اضافی از قسمتی از کروموزوم 12 (به نام ایزوکروموزوم 12p یا i12p) هستند. برخی از سرطانهای بیضه تغییراتی در سایر کروموزومها یا حتی تعداد غیرطبیعی کروموزومها (اغلب بیش از حد) دارند. دانشمندان در حال مطالعه این تغییرات DNA و کروموزوم هستند تا بیشتر در مورد ژنهایی که تحت تأثیر قرار میگیرند و اینکه چگونه ممکن است منجر به سرطان بیضه شوند، بیاموزند.
عوامل خطرزا برای سرطان بیضه
عامل خطرزا هر چیزی است که شانس ابتلا به بیماری مانند سرطان را تغییر دهد. سرطانهای مختلف عوامل خطرزای متفاوتی دارند. برخی از عوامل خطرزا مانند سیگار کشیدن و رژیم غذایی را میتوان تغییر داد. موارد دیگر، مانند سن یا سابقه خانوادگی فرد، قابل تغییر نیستند.
اما داشتن یک عامل خطرزا یا حتی تعداد زیادی از آنها به این معنی نیست که شما به این بیماری مبتلا خواهید شد. همان طور که نداشتن عوامل خطرزا به این معنی نیست که به این بیماری مبتلا نخواهید شد. برخی از افرادی که به این بیماری مبتلا میشوند ممکن است هیچ عامل خطرزای شناخته شده ای نداشته باشند. حتی اگر یک فرد مبتلا به سرطان بیضه دارای یک عامل خطرزا باشد، اغلب بسیار سخت است که بدانیم این عامل خطرزا چقدر در ایجاد سرطان نقش داشته است.
دانشمندان عوامل خطرزای کمی را یافته اند که احتمال ابتلا به سرطان بیضه را افزایش میدهد. اکثر پسران و مردان مبتلا به سرطان بیضه هیچ یک از عوامل خطرزای شناخته شده را ندارند. عوامل خطرزای سرطان بیضه عبارتند از:
- بیضه نزول نکرده
- سابقه خانوادگی سرطان بیضه
- عفونت HIV
- کارسینوم درجا بیضه
- داشتن سرطان بیضه قبلا
- بودن از یک نژاد یا قومیت خاص
- اندازه بدن
بیضه نزول نکرده
یکی از عوامل خطرزا اصلی سرطان بیضه وضعیتی به نام کریپتورکیدیسم (cryptorchidism) یا بیضه(های) نزول نکرده است. این بدان معنی است که یک یا هر دو بیضه قبل از تولد از شکم (belly) به داخل کیسه بیضه حرکت نمیکنند. مردان مبتلا به کریپتورکیدیسم چندین برابر بیشتر از آنهایی که بیضههای معمولی نزول دارند در معرض ابتلا به سرطان بیضه هستند.

به طور معمول، بیضهها در داخل شکم جنین رشد میکنند و قبل از تولد به داخل کیسه بیضه پایین میروند. اما در حدود 3 درصد از پسران، بیضهها تا قبل از تولد کودک پایین نمیآیند. گاهی اوقات یک یا هر دو بیضه در شکم میمانند. در موارد دیگر، بیضهها شروع به پایین آمدن میکنند اما در ناحیه کشاله ران باقی میمانند.
بیشتر اوقات، بیضههای نزول نکرده در سال اول زندگی کودک به سمت پایین به داخل کیسه بیضه حرکت میکنند. اگر تا زمانی که کودک یک ساله شده است، بیضه پایین نیامده است، احتمالاً به تنهایی این کار را انجام نخواهد داد. گاهی اوقات برای انتقال بیضه به سمت پایین به داخل کیسه بیضه به یک روش جراحی معروف به ارکیوپکسی (orchiopexy) نیاز است.
خطر ابتلا به سرطان بیضه ممکن است برای مردانی که بیضهشان در شکم باقی مانده است، کمی بیشتر باشد، در مقایسه با بیضهای که حداقل تا نیمه پایین آمده است. اگر سرطان ایجاد شود، معمولاً در بیضه نزول نکرده ایجاد میشود اما حدود 1 مورد از هر 4 مورد در بیضه دارای نزول طبیعی رخ میدهد. به همین دلیل، برخی از پزشکان به این نتیجه میرسند که کریپتورکیدیسم در واقع باعث سرطان بیضه نمیشود، بلکه چیز دیگری هم به سرطان بیضه و هم به موقعیت غیرعادی یک یا هر دو بیضه منجر میشود.
اورکیوپکسی ممکن است خطر ابتلا به سرطان بیضه را در صورتی که در کودک کوچکتر انجام شود کاهش دهد اما به وضوح مشخص نیست که اگر کودک بزرگتر باشد چقدر مفید است. بهترین زمان انجام این جراحی مشخص نیست. متخصصان در ایالات متحده توصیه میکنند که به دلایل غیر مرتبط با سرطان (مانند باروری) بلافاصله پس از اولین تولد کودک، اورکیوپکسی انجام شود.
سابقه خانوادگی
داشتن پدر یا برادر مبتلا به سرطان بیضه، خطر ابتلا به این بیماری را در فرد نیز افزایش میدهد. اما فقط تعداد کمی از سرطانهای بیضه در خانوادهها رخ میدهد. اکثر مردان مبتلا به سرطان بیضه سابقه خانوادگی ابتلا به این بیماری را ندارند.
سندرم کلاین فلتر (Klinefelter’s syndrome) یک بیماری ارثی است که با افزایش خطر ابتلا به سرطان بیضه نیز مرتبط است.

عفونت HIV
برخی از شواهد نشان داده اند که مردان آلوده به ویروس نقص ایمنی انسانی (HIV)، به ویژه افراد مبتلا به ایدز، در معرض خطر بیشتری برای ابتلا به این نوع سرطان هستند. هیچ عفونت دیگری برای افزایش خطر سرطان بیضه نشان داده نشده است.
کارسینوم درجا (Carcinoma in situ)
این عارضه، اغلب باعث ایجاد توده در بیضهها یا علائم دیگری نمیشود. مشخص نیست که چند بار کارسینوم درجا (CIS) در بیضهها به سرطان تبدیل میشود. در برخی موارد، CIS در مردانی یافت میشود که برای ارزیابی ناباروری بیوپسی بیضه انجام میدهند یا به دلیل کریپتورکیدیسم بیضه برداشته میشود. پزشکان در اروپا بیشتر از پزشکان آمریکا به دنبال CIS هستند. به همین دلیل است که تعداد تشخیص و پیشرفت CIS به سرطان در ایالات متحده کمتر از بخشهایی از اروپا است.
از آن جایی که نمیدانیم هر چند وقت یکبار CIS به سرطان واقعی (تهاجمی) تبدیل میشود، مشخص نیست که آیا درمان CIS ایده خوبی است یا خیر. برخی از متخصصان فکر میکنند که بهتر است منتظر بمانیم و ببینیم که آیا بیماری بدتر شده یا به یک سرطان واقعی تبدیل میشود یا خیر. این امر میتواند به بسیاری از مردان مبتلا به CIS اجازه دهد تا از خطرات و عوارض جانبی روند درمان اجتناب کنند. هنگامی که CIS درمان میشود، از پرتو درمانی یا جراحی (برای برداشتن بیضه) استفاده میشود.
سرطان در بیضه دیگر
سابقه شخصی سرطان بیضه یکی دیگر از عوامل خطرزا است. حدود 3 یا 4 درصد از مردانی که سرطان در یک بیضه آنها درمان شده است، در یک مقطع زمانی به سرطان بیضه دیگر مبتلا میشوند.
سن
حدود نیمی از سرطانهای بیضه در مردان بین 20 تا 34 سال رخ میدهد. اما این سرطان میتواند مردان را در هر سنی از جمله نوزادان و مردان مسن درگیر کند.
نژاد و قومیت
خطر ابتلا به سرطان بیضه در میان مردان سفید پوست حدود 4 تا 5 برابر مردان سیاه پوست و آسیایی-آمریکایی است. میزان خطر ابتلا برای سرخپوستان آمریکا چیزی بین این مقدار در آسیاییها و سفیدپوستان است. دلیل این تفاوتها مشخص نیست. در سرتاسر جهان، خطر ابتلا به این بیماری در میان مردان ساکن در ایالات متحده و اروپا بیشترین مقدار و در میان مردان ساکن آفریقا یا آسیا کمتر است.
اندازه بدن
چندین مطالعه نشان داده است که مردان قد بلند تا حدودی بیشتر در معرض خطر ابتلا به سرطان بیضه هستند اما برخی مطالعات دیگر چنین چیزی را نشان ندادند. اکثر مطالعات، ارتباطی را بین سرطان بیضه و وزن بدن پیدا نکرده اند.
عوامل خطرزا اثبات نشده یا بحث برانگیز
آسیب یا ضربه قبلی به بیضهها و اقدامات مکرر مانند اسب سواری به نظر نمیرسد با ایجاد سرطان بیضه مرتبط باشد.
اکثر مطالعات نشان نداده اند که فعالیت بدنی شدید خطر ابتلا به سرطان بیضه را افزایش میدهد. فعال بودن بدنی با کاهش خطر ابتلا به انواع دیگر سرطان و همچنین کاهش خطر ابتلا به بسیاری از مشکلات دیگر مرتبط است.
آیا میتوان از ابتلا به سرطان بیضه پیشگیری کرد؟
بسیاری از مردان مبتلا به سرطان بیضه هیچ عامل خطرزای شناخته شده ای ندارند. برخی از عوامل خطرزای شناخته شده مانند بیضههای نزول نکرده، نژاد سفید و سابقه خانوادگی بیماری را نمیتوان تغییر داد. به این دلایل، در حال حاضر امکان پیشگیری از اکثر موارد این بیماری وجود ندارد.
کارشناسان اصلاح کریپتورکیدیسم در پسران را به دلایل متعددی توصیه میکنند (مانند حفظ باروری و تصویر بدن) اما مشخص نیست که این امر تا چه اندازه خطر ابتلا به سرطان بیضه را در کودک تغییر میدهد.
نرخ بقای سرطان بیضه
میزان بقا میتواند به شما این ایده را بدهد که چند درصد از افراد مبتلا به همان نوع و مرحله سرطان تا مدت معینی (معمولاً 5 سال) پس از تشخیص هنوز زنده هستند. این اعداد نمیتوانند به شما بگویند که چقدر زنده خواهید ماند اما ممکن است به شما کمک کنند تا درک بهتری از احتمال موفقیت روند درمانی خود داشته باشید.
به خاطر داشته باشید که میزان بقا تخمینی است و اغلب بر اساس نتایج قبلی تعداد زیادی از افرادی است که سرطان خاصی داشتند اما آنها نمیتوانند پیش بینی کنند که در مورد فرد خاصی چه اتفاقی خواهد افتاد. این آمار میتواند گیج کننده باشد و ممکن است شما را به پرسیدن سوالات بیشتری سوق دهد. با پزشک خود در مورد نحوه اعمال این اعداد برای خود صحبت کنید.
نرخ بقای نسبی 5 ساله چیست؟
نرخ بقای نسبی افراد مبتلا به همان نوع و مرحله سرطان را با افراد موجود در کل جمعیت مقایسه میکند. به عنوان مثال، اگر میزان بقای نسبی 5 ساله برای مرحله خاصی از سرطان بیضه 90 درصد باشد، به این معنی است که احتمال زنده ماندن برای 5 سال آینده پس از تشخیص در افرادی که به آن سرطان مبتلا هستند، به طور متوسط حدود 90 درصد بیشتر از افرادی است که به آن سرطان مبتلا نیستند.
این اعداد از کجا میآیند؟
انجمن سرطان آمریکا به اطلاعات پایگاه داده SEER که توسط موسسه ملی سرطان (National Cancer Institute یا NCI) نگهداری میشود، برای ارائه آمار بقای انواع مختلف سرطان متکی است.
پایگاه داده SEER نرخ بقای نسبی 5 ساله سرطان بیضه در ایالات متحده را بر اساس میزان گسترش سرطان دنبال میکند. با این حال، پایگاه داده SEER سرطانها را بر اساس مراحل AJCC TNM (مرحله 1، مرحله 2، مرحله 3 و غیره) گروه بندی نمیکند. در عوض، سرطانها را به مراحل موضعی، منطقه ای و دور دسته بندی میکند:
- موضعی (Localized): هیچ نشانه ای از گسترش سرطان در خارج از بیضه وجود ندارد.
- منطقه ای (Regional): سرطان در خارج از بیضه به ساختارها یا غدد لنفاوی مجاور گسترش یافته است.
- دور (Distant): سرطان به نقاط دورتر بدن مانند ریه، کبد یا غدد لنفاوی دور گسترش یافته است.
نرخ بقای نسبی 5 ساله برای سرطان بیضه
این اعداد بر أساس اطلاعات افرادی به دست آمده است که بین سالهای 2011 تا 2017 به سرطان بیضه مبتلا شده اند.

درک اعداد
- این اعداد فقط برای مرحله سرطان در هنگام اولین تشخیص صدق میکند. اگر سرطان رشد کند، گسترش یابد یا پس از درمان عود کند، بعداً اعمال نمیشوند.
- این اعداد همه چیز را در نظر نمیگیرند. این نرخهای بقا بر اساس میزان گسترش سرطان گروه بندی میشوند. اما عوامل دیگر، از جمله سن و سلامت کلی شما، نوع سرطان بیضه و اینکه سرطان چگونه به درمان پاسخ میدهد نیز میتواند بر دیدگاه شما تأثیر بگذارد. از پزشک خود بخواهید تا به شما توضیح دهد که چگونه این عامل یا عوامل دیگر ممکن است برای شما مهم باشند.
- افرادی که اکنون مبتلا به سرطان بیضه تشخیص داده میشوند، ممکن است چشم انداز بهتری نسبت به این اعداد داشته باشند. روشهای درمانی با گذشت زمان بهبود مییابند و این اعداد بر أساس اطلاعات افرادی بدست آمده اند که حداقل پنج سال زودتر تشخیص داده شده و درمان شده اند.
آیا سرطان بیضه زود تشخیص داده میشود؟
بیشتر سرطانهای بیضه را میتوان در مراحل اولیه، زمانی که کوچک هستند و گسترش نیافته اند، پیدا کرد. در برخی از مردان، سرطانهای اولیه بیضه علائمی ایجاد میکند که آنها را به دنبال دریافت مراقبتهای پزشکی سوق میدهد. اغلب اوقات مشاهده یک توده روی بیضه اولین علامت است یا ممکن است بیضه متورم یا بزرگتر از حد طبیعی باشد اما برخی از سرطانهای بیضه ممکن است تا زمانی که به مراحل پیشرفته نرسند علائمی ایجاد نکنند.
اکثر پزشکان موافق هستند که معاینه بیضههای یک مرد باید بخشی از یک معاینه فیزیکی عمومی در طی یک معاینه معمول باشد.
برخی از پزشکان توصیه میکنند که همه مردان پس از بلوغ هر ماه بیضه خود را معاینه کنند. هر مردی باید خودش تصمیم بگیرد که این کار را انجام دهد یا نه، بنابراین دستورالعملهای مربوط به معاینه بیضه در این قسمت گنجانده شده است. اگر عوامل خطرزای خاصی دارید که شانس ابتلا به سرطان بیضه را افزایش میدهد (مانند بیضه نزول نکرده، وجود تومور سلول زایا قبلی در یک بیضه یا سابقه خانوادگی)، باید به طور جدی خودآزمایی ماهانه را در نظر بگیرید و در مورد آن با پزشک خود صحبت کنید.
انجمن سرطان آمریکا به مردان توصیه میکند که از سرطان بیضه آگاه باشند و در صورت یافتن توده در بیضه فوراً به پزشک مراجعه کنند. از آن جایی که خودآزمایی منظم بیضه به اندازه کافی مورد مطالعه قرار نگرفته است تا مشخص شود که آیا میزان مرگ و میر ناشی از این سرطان را کاهش میدهد یا خیر، ACS توصیه ای در مورد خودآزمایی منظم بیضه برای همه مردان ندارد.
خودآزمایی بیضه
بهترین زمان برای معاینه بیضهها در حین یا بعد از حمام یا دوش گرفتن است، زمانی که پوست کیسه بیضه شل است.
- آلت تناسلی خود را بالا نگه دارید و هر بیضه را جداگانه بررسی کنید.
- بیضه خود را با دو دست بین شست و انگشتان خود نگه دارید و به آرامی بین انگشتان خود بچرخانید.
- هر گونه توده یا گره سخت (تودههای گرد صاف) یا هر گونه تغییر در اندازه، شکل یا قوام بیضهها را مشاهده و احساس کنید.
طبیعی است که یک بیضه کمی بزرگتر از دیگری و یکی پایین تر از دیگری آویزان باشد. همچنین باید توجه داشته باشید که هر بیضه طبیعی دارای یک لوله کوچک و پیچیده به نام اپیدیدیم است که میتواند مانند یک برآمدگی کوچک در سمت بیرونی فوقانی یا میانی بیضه احساس شود. بیضههای طبیعی همچنین حاوی رگهای خونی، بافتهای حمایت کننده و لولههایی هستند که اسپرم را حمل میکنند. برخی از مردان ممکن است در ابتدا این موارد را با تودههای غیر طبیعی اشتباه بگیرند. اگر نگرانیای دارید، از پزشک خود دربارهی آنها سوال بپرسید.
بیضه به دلایل زیادی به جز سرطان میتواند بزرگتر شود. به عنوان مثال، مایع میتواند در اطراف بیضه جمع شود و هیدروسل (hydrocele) تشکیل دهد. یا وریدهای بیضه میتوانند گشاد شوند و باعث بزرگ شدن و برآمدگی اطراف بیضه شوند. به این حالت واریکوسل (varicocele) میگویند. اگر بیضه شما بزرگتر از حد طبیعی به نظر میرسد، از پزشک بخواهید که شما را معاینه کند تا مطمئن شود که به یکی از این شرایط مبتلا شده اید نه تومور. پزشک ممکن است آزمایش سونوگرافی را تجویز کند (به مبحث آزمایشات سرطان بیضه در ادامه مراجعه کنید). این یک راه آسان و بدون درد برای یافتن تومور است.
اگر تصمیم بگیرید که بیضههای خود را به طور منظم معاینه کنید، متوجه خواهید شد که چه چیزی طبیعی است و چه چیزی متفاوت است. همیشه هر گونه تغییر را بدون تاخیر به پزشک خود گزارش دهید.
آزمایشات سرطان بیضه
سرطان بیضه معمولاً در نتیجه علائمی که فرد دارد پیدا میشود. همچنین هنگامی که آزمایشات برای شرایط دیگری انجام میشود، میتوان آن را یافت. مرحله بعدی معاینه توسط پزشک است.
پزشک بیضهها را از نظر تورم یا حساسیت و اندازه و محل هر توده ای بررسی میکند. پزشک همچنین شکم (belly)، غدد لنفاوی و سایر قسمتهای بدن شما را به دقت بررسی میکند تا نشانههای گسترش سرطان را بیابد. اغلب نتایج امتحان غیر از تغییرات در بیضهها طبیعی است. اگر توده یا نشانه دیگری از سرطان بیضه یافت شود، آزمایش برای یافتن علت مورد نیاز است.
سونوگرافی بیضهها (Ultrasound of the testicles)
اگر پزشک فکر کند ممکن است سرطان بیضه داشته باشید، سونوگرافی اغلب اولین آزمایشی است که انجام میشود. این روش از امواج صوتی برای تولید تصاویری از داخل بدن شما استفاده میکند. میتوان از آن برای مشاهده اینکه آیا تغییر، یک وضعیت خوش خیم خاص (مانند هیدروسل یا واریکوسل) یا یک تومور جامد است که میتواند سرطانی باشد، استفاده کرد. اگر توده جامد باشد، به احتمال زیاد سرطان است. در این مورد، پزشک ممکن است آزمایشهای دیگری یا حتی جراحی برای برداشتن بیضه را توصیه کند.
آزمایش خون برای بررسی نشانگرهای تومور
برخی از آزمایشات خون میتواند به تشخیص تومورهای بیضه کمک کند. بسیاری از سرطانهای بیضه سطوح بالایی از پروتئینهای خاصی به نام نشانگرهای تومور مانند آلفا فتوپروتئین (AFP) و گنادوتروپین جفتی انسانی (HCG) را تولید میکنند. وقتی این نشانگرهای تومور در خون هستند، نشان میدهد که یک تومور در بیضه وجود دارد.
افزایش سطح AFP یا HCG همچنین میتواند به پزشکان در تشخیص نوع سرطان بیضه کمک کند.
- غیر سمینوما اغلب سطوح AFP و یا HCG را افزایش میدهند.
- سمینومهای خالص گهگاه سطوح HCG را افزایش میدهند اما هرگز سطح AFP را افزایش نمیدهند.
این بدان معنی است که هر گونه افزایش در AFP نشانه آن است که تومور دارای یک جزء غیر سمینومایی است. (تومورها میتوانند مخلوط باشند و دارای نواحی سمینوما و غیر سمینوما باشند.) تومورهای سلولی سرتولی و لیدیگ این مواد را نمیسازند. توجه به این نکته مهم است که برخی از سرطانها برای افزایش سطح نشانگرهای تومور بسیار کوچک هستند.
تومور بیضه همچنین ممکن است سطح آنزیمی به نام لاکتات دهیدروژناز (LDH) را افزایش دهد. سطح بالای LDH اغلب (اما نه همیشه) نشان دهنده بیماری گسترده است. اما سطح LDH در برخی شرایط غیر سرطانی نیز افزایش مییابد.
آزمایشهای نشانگر تومور گاهی به دلایل دیگری نیز مورد استفاده قرار میگیرند، مانند کمک به تخمین میزان وجود سرطان (به مبحث مراحل سرطان بیضه مراجعه کنید) تا بررسی شود که روند درمان چقدر خوب کار میکند یا برای جستجوی نشانههایی که نشان دهد سرطان ممکن است عود کرده باشد.

جراحی برای تشخیص سرطان بیضه
اکثر انواع سرطان با برداشتن یک قطعه کوچک از تومور و مشاهده آن در زیر میکروسکوپ برای سلولهای سرطانی تشخیص داده میشوند. این روش به عنوان بیوپسی (biopsy) شناخته میشود. اما بیوپسی به ندرت برای تومور بیضه انجام میشود زیرا ممکن است خطر گسترش سرطان را داشته باشد. پزشک اغلب بر اساس سونوگرافی و آزمایشهای نشانگر تومور خون، میتواند ایده خوبی درباره سرطان بیضه پیدا کند، بنابراین به جای بیوپسی، پزشک به احتمال زیاد جراحی (ارکیکتومی رادیکال اینگوینال یا radical inguinal orchiectomy) را برای برداشتن تومور در اسرع وقت توصیه میکند.
کل بیضه به آزمایشگاه فرستاده میشود، جایی که یک پاتولوژیست (پزشک متخصص در تشخیص آزمایشگاهی بیماریها) با میکروسکوپ به تکههایی از تومور نگاه میکند. اگر سلولهای سرطانی یافت شوند، آسیب شناس گزارشی را ارسال میکند که نوع و وسعت سرطان را شرح میدهد.
در موارد بسیار نادر، زمانی که تشخیص سرطان بیضه نامشخص است، پزشک ممکن است قبل از برداشتن بیضه بیوپسی انجام دهد. این کار در اتاق عمل انجام میشود. جراح برشی در بالای ناحیه شرمگاهی ایجاد میکند، بیضه را از کیسه بیضه خارج میکند و بدون بریدن طناب اسپرماتیک آن را معاینه میکند. در صورت مشاهده ناحیه مشکوک، قسمتی از آن برداشته شده و بلافاصله توسط پاتولوژیست بررسی میشود. اگر سرطان پیدا شود، بیضه و طناب اسپرماتیک خارج میشوند. اگر بافت سرطانی نباشد، بیضه را اغلب میتوان به کیسه بیضه بازگرداند.
اگر سرطان بیضه پیدا شود، پزشک آزمایشهای تصویربرداری از سایر قسمتهای بدن شما را برای بررسی انتشار در خارج از بیضه تجویز میکند. این آزمایشات همچنین ممکن است قبل از تایید تشخیص توسط جراحی انجام شود.
تستهای تصویربرداری
تستهای تصویربرداری از اشعه ایکس، میدانهای مغناطیسی، امواج صوتی یا مواد رادیواکتیو برای ایجاد تصاویری از داخل بدن شما استفاده میکنند. سونوگرافی بیضه که در بالا توضیح داده شد، نوعی آزمایش تصویربرداری است. سایر آزمایشات تصویربرداری ممکن است به دلایل مختلفی پس از تشخیص سرطان بیضه انجام شود، از جمله:
- برای فهم اینکه آیا سرطان ممکن است گسترش یافته باشد یا نه.
- برای کمک به تعیین اینکه آیا روند درمان مؤثر بوده است یا خیر.
- برای جستجوی علائم احتمالی سرطان پس از گذشت دوره درمان.
اشعه ایکس قفسه سینه
ممکن است قفسه سینه شما رادیوگرافی شود تا مشخص شود آیا سرطان به ریههای شما سرایت کرده است یا خیر.
اسکن توموگرافی کامپیوتری (Computed tomography یا CT)

سی تی اسکن میتواند برای کمک به تعیین مرحله (وسعت) سرطان با نشان دادن اینکه آیا به غدد لنفاوی، ریهها، کبد یا سایر اندامها گسترش یافته است، استفاده شود.
اسکن تصویر برداری رزونانس مغناطیسی (MRI یا Magnetic resonance imaging)
اسکن MRI برای بررسی مغز و نخاع بسیار خوب است. این روش فقط در صورتی در بیماران مبتلا به سرطان بیضه انجام میشود که پزشک دلیلی داشته باشد که فکر کند سرطان به آن نواحی گسترش یافته است.
اسکن توموگرافی گسیل پوزیترون (PET یا Positron emission tomography)
اسکن PET میتواند به شناسایی مجموعههای کوچکی از سلولهای سرطانی در بدن کمک کند. گاهی اوقات مشاهده اینکه آیا غدد لنفاوی که بعد از شیمی درمانی دوباره بزرگ شده اند حاوی سرطان اند یا فقط بافت زخم هستند، مفید است. اسکن PET اغلب برای سمینوما مفیدتر از غیر سمینوما است، بنابراین در بیماران مبتلا به غیر سمینوما کمتر مورد استفاده قرار میگیرد. بسیاری از مراکز دارای دستگاههای ویژه ای هستند که میتوانند هم زمان PET و هم سی تی اسکن (PET/CT scan) را انجام دهند. این کار به پزشک امکان میدهد مناطق پرتوزای بالاتر در PET را با تصاویر دقیق تر CT مقایسه کند.
اسکن استخوان
اسکن استخوان میتواند نشان دهد که آیا سرطان به استخوانها سرایت کرده است یا خیر. اگر دلیلی وجود داشته باشد که فکر کنیم سرطان ممکن است به استخوانها گسترش یافته باشد (به دلیل علائمی مانند درد استخوان) و اگر نتایج آزمایشات دیگر واضح نباشد، این روش ممکن است انجام شود.
مراحل سرطان بیضه
پس از تشخیص سرطان بیضه در فردی، پزشکان سعی میکنند بفهمند که آیا این سرطان گسترش یافته است یا خیر و اگر چنین است، این گسترش تا چه حد است. این فرآیند مرحله بندی (staging) نامیده میشود. مرحله سرطان، میزان سرطان در بدن را توصیف میکند. این کار به تعیین اینکه سرطان چقدر جدی است و بهترین روش درمان آن کمک میکند. پزشکان همچنین هنگام صحبت در مورد آمار بقا و زنده مانی از مرحله سرطان استفاده میکنند.
اولیه ترین مرحله سرطان بیضه مرحله 0 است (که به آن نئوپلازی سلول زایای درجا یا germ cell neoplasia in situ یا GCNIS نیز میگویند). گروه بندی مرحلهای دیگر از I (1) تا III (3) متغیر است. مرحله IV (4) سرطان بیضه وجود ندارد. برخی از مراحل برای پوشش جزئیات بیشتر با استفاده از حروف بزرگ (A، B و غیره) بیشتر تقسیم میشوند.
به عنوان یک قاعده، هرچه این عدد کمتر باشد، سرطان کمتر گسترش یافته است. عدد بالاتر، مانند مرحله III، به معنای گسترش بیشتر سرطان است. در یک مرحله، حرف قبل به معنای مرحله پایین تر است. اگرچه تجربه سرطان هر فرد منحصربهفرد است، سرطانهایی که مراحل مشابه دارند، چشمانداز مشابهی دارند و اغلب به روشی مشابه نیز درمان میشوند.
مرحله چگونه تعیین میشود؟
سیستم مرحله بندی که اغلب برای سرطان بیضه استفاده میشود، سیستم TNM کمیته مشترک آمریکایی سرطان (American Joint Committee on Cancer یا AJCC) است که بر اساس 4 اطلاعات کلیدی است:
- اندازه و وسعت تومور اصلی (T): اندازه تومور چقدر است؟ آیا به ساختارها یا اندامهای مجاور رشد کرده است؟
- گسترش به غدد لنفاوی مجاور (N): آیا سرطان به غدد لنفاوی مجاور سرایت کرده است؟ غدد لنفاوی درگیر چند تا هستند و چقدر بزرگ میباشند؟
- گسترش (متاستاز) به نقاط دوردست (M): آیا سرطان به نقاط دوردست بدن گسترش یافته است؟ (شایع ترین محل انتشار غدد لنفاوی دور، استخوانها، کبد و ریهها هستند.)
- سطح سرمی (خون) نشانگرهای تومور (S): آیا سطوح نشانگر تومور بالاتر از حد طبیعی است؟ این شامل لاکتات دهیدروژناز (lactate dehydrogenase یا LDH)، گنادوتروپین جفتی انسانی (HCG) و آلفا فتوپروتئین (AFP) است.
اعداد یا حروف بعد از T، N، M و S جزئیات بیشتری در مورد هر یک از این عوامل ارائه میدهند. اعداد بالاتر به معنای پیشرفته تر بودن سرطان است. هنگامی که دسته بندیهای T، N، M و S شخص مشخص شد، این اطلاعات در فرآیندی به نام گروه بندی مرحله ای (stage grouping) با یکدیگر ترکیب میشوند تا یک مرحله کلی را تعیین کنند.
سیستم توضیح داده شده در زیر جدیدترین سیستم AJCC است که از ژانویه 2018 قابل اجرا شده است. این سیستم برای تومورهای سلول زایا (سمینوم و غیر سمینوم) که بعد از بلوغ ایجاد و برای تومورهای استرومای طناب جنسی (تومورهای سلول لیدیگ و تومورهای سلول سرتولی) استفاده میشوند.
سرطان بیضه ممکن است بر اساس نتایج معاینه فیزیکی، بیوپسی و تستهای تصویر برداری (همان طور که در تستهای سرطان بیضه توضیح داده شده است) یک دسته T بالینی (نوشته شده به عنوان cT) داده شود. پس از انجام جراحی، دسته پاتولوژیک T (نوشته شده به صورت pT) با بررسی بافت برداشته شده در طول عمل تعیین میشود.
مرحله بندی سرطان بیضه میتواند پیچیده باشد، بنابراین از پزشک خود بخواهید آن را به گونه ای که شما درک میکنید برایتان توضیح دهد.
درمان سرطان بیضه
اگر سرطان بیضه برای شما تشخیص داده شده است، تیم درمانی شما گزینههای مناسبتان را با شما در میان میگذارد. مهم است که مزایای هر گزینه درمانی را در مقابل خطرات و عوارض جانبی احتمالی بسنجید.
جراحی (Surgery) برای سرطان بیضه
جراحی اولین روش درمانی برای تقریباً تمام سرطانهای بیضه است.
ارکیکتومی رادیکال اینگوینال (Radical inguinal orchiectomy)
جراحی برای برداشتن بیضه مبتلا به سرطان، ارکیکتومی رادیکال اینگوینال نامیده میشود. یک برش درست در بالای ناحیه شرمگاهی ایجاد میشود و بیضه به آرامی از طریق دهانه از کیسه بیضه خارج میشود. سپس جراح کل تومور را به همراه بیضه و طناب اسپرماتیک برمیدارد. طناب اسپرماتیک شامل بخشی از مجرای دفران و همچنین عروق خونی و لنفاوی است که میتواند به عنوان مسیری برای گسترش سرطان بیضه به بقیه بدن عمل کند. برای کاهش این احتمال، این بخشها در اوایل عملیات بسته میشوند.
همه سرطانهای بیضه به طور معمول با این جراحی درمان میشوند، حتی سرطانهایی که گسترش یافته اند.
تشریح غدد لنفاوی خلفی صفاقی (RPLND یا Retroperitoneal lymph node dissection)

بسته به نوع و مرحله سرطان شما، غدد لنفاوی اطراف رگهای خونی بزرگ (آئورت و ورید اجوف تحتانی) در پشت شکم ممکن است همزمان با ارکیکتومی یا در طی عمل دوم برداشته شوند. همه افراد مبتلا به سرطان بیضه نیازی به برداشتن غدد لنفاوی ندارند، بنابراین مهم است که در این مورد (و گزینههای آن) با پزشک خود صحبت کنید.
این یک عملیات پیچیده و طولانی است. در بیشتر موارد، یک برش بزرگ در وسط شکم برای برداشتن غدد لنفاوی ایجاد میشود. RPLND باید توسط جراح انجام شود که اغلب این کار را انجام میدهد. تجربه جراحی فاکتوری مهم است.
جراحی لاپاروسکوپی (Laparoscopic surgery)
در برخی موارد، جراح میتواند غدد لنفاوی را از طریق برشهای پوستی بسیار کوچک در شکم با استفاده از لاپاراسکوپ و سایر ابزارهای جراحی بلند و نازک خارج کند. لاپاراسکوپ یک لوله باریک و نورانی با دوربین کوچک در انتهای آن است که به پزشکان اجازه میدهد داخل شکم را ببینند. در این نوع جراحی دستهای جراح در داخل بدن بیمار قرار نمیگیرد.
در جراحی لاپاراسکوپی، پس از بیهوش شدن، به پهلو چرخانیده میشوید. چندین برش کوچک روی شکم شما ایجاد میشود. لاپاراسکوپ و ابزارهای جراحی از طریق برشها برای برداشتن غدد لنفاوی وارد میشوند. سپس برشها بسته میشوند و شما از حالت بیهوشی خارج میشوید.
بیماران انجام دهنده این عمل خیلی سریعتر از روش باز استاندارد بهبود مییابند و خیلی زود بعد از عمل راه میروند. در این روش معمولاً درد کمتری وجود دارد و بیماران زودتر غذا میخورند.
به نظر میرسد جراحی لاپاراسکوپی برای بیمار بسیار آسانتر است اما پزشکان مطمئن نیستند که آیا این جراحی به اندازه جراحی استاندارد “باز” در برداشتن همه غدد لنفاوی که ممکن است حاوی سرطان باشد، ایمن و موثر باشد یا خیر. به دلیل این عدم قطعیت، اگر سرطان در غدد لنفاوی یافت شود، پزشکان پس از جراحی لاپاراسکوپی شیمی درمانی را بیشتر توصیه میکنند.
این روش اغلب برای بیماران مبتلا به غیر سمینوما در مراحل اولیه استفاده میشود تا ببینند آیا غدد لنفاوی حاوی سرطان هستند یا خیر. مانند روش استاندارد باز، این یک عمل پیچیده است که تنها در صورتی باید انجام شود که جراح بسیار با تجربه باشد.
خطرات و عوارض احتمالی جراحی
خطرات کوتاه مدت هر نوع جراحی شامل واکنش به بیهوشی، خونریزی زیاد، لخته شدن خون و عفونت است. اکثر مردان پس از عمل حداقل مقداری درد خواهند داشت که در صورت نیاز میتوان با داروهای ضد درد به آنها کمک کرد.
اثرات ارکیکتومی
از دست دادن یک بیضه معمولاً تأثیری بر توانایی مرد برای نعوظ و رابطه جنسی ندارد. اما اگر هر دو بیضه برداشته شود، نمیتوان اسپرم ساخت و مرد نابارور میشود. همچنین، بدون بیضه، یک مرد نمیتواند تستوسترون کافی تولید کند که همین امر میتواند میل جنسی را کاهش دهد و بر توانایی او برای داشتن نعوظ تأثیر بگذارد. اثرات دیگر میتواند شامل خستگی، گر گرفتگی و از دست دادن توده عضلانی باشد. از بروز این عوارض جانبی میتوان با مصرف مکملهای تستوسترون، چه به صورت ژل، یک پچ یا یک شات، پیشگیری کرد. قرصها به طور کلی منابع قابل اعتماد تستوسترون نیستند.
معمولاً مردان مبتلا به سرطان بیضه جوان هستند و ممکن است نگران تغییرات ظاهری خود باشند. آنها ممکن است با هم قرار ملاقات داشته باشند و در مورد واکنش شریک خود نگران باشند یا ممکن است ورزشکار باشند و در رختکن از نبود بیضه خود احساس خجالت کنند.
برای بازگرداندن ظاهر طبیعی تر، یک مرد میتواند یک پروتز بیضه را با جراحی در کیسه بیضه خود بکارد. پروتز مورد تایید برای استفاده در ایالات متحده با نمک (آب نمک) پر شده است و در اندازههای مختلف برای مطابقت با بیضه باقی مانده وجود دارد. هنگامی که این پروتز در جای خود قرار میگیرد، میتواند مانند یک بیضه طبیعی به نظر برسد.
ممکن است بعد از عمل یک اسکار (زخم) وجود داشته باشد اما اغلب تا حدی توسط موهای ناحیه تناسلی پنهان میشود. برخی از مردان ممکن است پروتز بخواهند، در حالی که برخی دیگر ممکن است این درخواست را نداشته باشند. قبل از جراحی باید خواستههای خود را با جراح خود در میان بگذارید. همچنین صحبت با کسی که پروتز بیضه گذاشته است میتواند به شما کمک کند تا متوجه شوید که برای او چه اتفاقی افتاده است.
اثرات تشریح غدد لنفاوی
جراحی برای برداشتن غدد لنفاوی خلف صفاقی یک عمل بزرگ است. عوارض جدی شایع نیستند اما ممکن است رخ دهند. حدود 5 تا 10 درصد از بیماران پس از جراحی مشکلات کوتاه مدتی مانند عفونت یا انسداد روده (blockage) دارند. روش استاندارد برای RPLND نیاز به یک برش بزرگ در شکم دارد که یک اسکار باقی میگذارد و ممکن است مدتی طول بکشد تا بهبود یابد.
توانایی شما برای بلند شدن و دور زدن بعد از عمل برای مدتی محدود خواهد بود. در صورت انجام جراحی لاپاراسکوپی که از برشهای کوچکتر استفاده میکند، احتمال کمتری وجود دارد که این مشکل ایجاد شود.
این نوع جراحی باعث ناتوانی جنسی نمیشود – مرد همچنان میتواند نعوظ و رابطه جنسی داشته باشد. اما ممکن است به برخی از اعصاب کنترل کننده انزال آسیب برساند. اگر این اعصاب آسیب ببینند، هنگام انزال مرد، مایع منی از مجرای ادرار خارج نمیشود تا از بدن خارج شود، بلکه به سمت عقب به مثانه میرود. این اتفاق انزال رتروگراد (retrograde ejaculation) نامیده میشود و میتواند پدر شدن را سخت کند.

برای حفظ عملکرد طبیعی انزال، جراحان نوعی از جراحی غدد لنفاوی خلفی صفاقی به نام جراحی حفظ أعصاب (nerve-sparing surgery) ایجاد کرده اند که زمانی که توسط پزشکان مجرب انجام شود، بسیار موفق است. سرطان بیضه اغلب مردان را در سنی تحت تاثیر قرار میدهد که ممکن است در تلاش برای بچه دار شدن باشند.
این مردان ممکن است بخواهند با پزشک خود در مورد جراحی حفظ اعصاب و همچنین استفاده از بانک اسپرم (انجماد و ذخیره سلولهای اسپرم به دست آمده قبل از درمان) صحبت کنند. مردان مبتلا به سرطان بیضه اغلب دارای تعداد اسپرم کمتر از حد طبیعی هستند که گاهی اوقات جمع آوری یک نمونه اسپرم خوب را دشوار میکند.
پرتو درمانی (Radiation Therapy) برای سرطان بیضه
پرتو درمانی از پرتوهای پرانرژی (مانند پرتوهای گاما یا اشعه ایکس) یا ذرات (مانند الکترون، پروتون یا نوترون) برای تخریب سلولهای سرطانی یا کاهش رشد آنها استفاده میکند. در درمان سرطان بیضه، پرتو به طور عمده برای از بین بردن سلولهای سرطانی که به غدد لنفاوی گسترش یافته اند، استفاده میشود.
نوعی از پرتو درمانی که در آن یک دستگاه پرتو را به قسمت خاصی از بدن میفرستد، به عنوان پرتو درمانی خارجی (external beam radiation) شناخته میشود. روند درمان بسیار شبیه به عکس برداری با اشعه ایکس است اما تابش قوی تر است. تشعشع ضرری ندارد. قبل از شروع دوره درمان شما، تیم پزشکی اندازهگیریهای دقیقی را برای تعیین زوایای صحیح برای نشانهگیری پرتوهای تابشی و دوز مناسب تابش انجام میدهد. هر جلسه درمانی فقط چند دقیقه طول میکشد اما زمان تنظیم – قرار دادن شما در موقعیت برای انجام پرتو درمانی – معمولاً بیشتر طول میکشد.
به طور کلی پرتو درمانی عمدتاً برای بیماران مبتلا به سمینوما که به اشعه بسیار حساس است، استفاده میشود. گاهی أوقات این روش پس از ارکیکتومی (عملیات برداشتن بیضه) استفاده و به سمت غدد لنفاوی پشت شکم (غدد لنفاوی خلفی صفاقی) هدایت میشود. این کار برای از بین بردن تکههای کوچک سرطان در غدد لنفاوی است که قابل مشاهده نیستند. همچنین میتواند برای درمان مقادیر کمی از سمینوم که به گرهها گسترش یافته است (بر اساس تغییرات مشاهده شده در CT و PET اسکن) استفاده شود.
همچنین گاهی اوقات از پرتو درمانی برای درمان سرطان بیضه (هم سمینوما و هم غیر سمینوما) که به اندامهای دور دست (مانند مغز) گسترش یافته است، استفاده میشود.
عوارض جانبی احتمالی پرتو درمانی
پرتو درمانی میتواند بافت سالم مجاور را همراه با سلولهای سرطانی تحت تاثیر قرار دهد. برای کاهش خطر عوارض جانبی، پزشکان با دقت دوز دقیق مورد نیاز شما را مشخص میکنند و پرتوها را برای برخورد با تومور هدایت میکنند. درمان سرطان بیضه اغلب از دوزهای کمتری نسبت به سایر انواع سرطان استفاده میکند.
عوارض جانبی رایج میتواند شامل موارد زیر باشد:
- خستگی
- حالت تهوع
- اسهال
برخی از مردان تغییرات پوستی مانند قرمزی، تاول یا پوسته پوسته شدن نیز دارند اما این تغییرات غیر معمول است.
این عوارض جانبی پس از اتمام پرتودهی با گذشت زمان بهتر میشوند. اگر تشعشع به بیضه سالم برسد میتواند بر باروری (تعداد اسپرم) تأثیر بگذارد، بنابراین یک سپر محافظ ویژه روی بیضه دیگر قرار میگیرد تا به محافظت از آن کمک کند.
تشعشع همچنین میتواند اثرات طولانی مدتی داشته باشد، مانند آسیب به رگهای خونی یا سایر اندامهای نزدیک غدد لنفاوی تحت درمان. همچنین میتواند باعث افزایش خطر ابتلا به سرطان دوم (خارج از بیضه) در آینده شود. این خطرات در گذشته زمانی که دوزهای بالاتر استفاده میشد و بافت بیشتری در معرض تشعشع قرار میگرفت، بیشتر بود.
شیمی درمانی (Chemotherapy) برای سرطان بیضه
شیمی درمانی (chemo) استفاده از داروها برای درمان سرطان است. این داروها را میتوان به شکل قرص بلعید یا میتوان آنها را با سوزن در ورید یا ماهیچه تزریق کرد. برای درمان سرطان بیضه، داروها معمولاً در ورید (IV) داده میشوند. ای نوع شیمی درمانی سیستمیک است. این بدان معنی است که دارو در سراسر بدن حرکت میکند تا به سلولهای سرطانی برسد و آنها را از بین ببرد. شیمی درمانی برای از بین بردن سلولهای سرطانی که از تومور اصلی جدا شده و به غدد لنفاوی یا سایر نقاط بدن میروند استفاده میشود.
شیمی درمانی اغلب برای درمان سرطان بیضه زمانی که در خارج از بیضه پخش شده است، استفاده میشود. همچنین برای کمک به کاهش خطر عود سرطان پس از برداشتن بیضه استفاده میشود. این روش برای درمان سرطانی که فقط در بیضه است، استفاده نمیشود.
داروهای شیمی درمانی استفاده شده
شیمی درمانی به صورت چرخه ای انجام میشود و هر دوره درمان با یک دوره استراحت همراه است تا به بدن زمان لازم برای بهبودی داده شود. سیکلهای شیمی درمانی به طور کلی حدود 3 تا 4 هفته طول میکشد. داروهای اصلی مورد استفاده برای درمان سرطان بیضه عبارتند از:
- سیس پلاتین (Cisplatin)
- اتوپوزید (VP-16)
- بلئومایسین (Bleomycin)
- ایفوسفامید (Ifex)
- پاکلیتاکسل (Taxol)
- وینبلاستین (Vinblastine)
استفاده از 2 یا چند داروی شیمی درمانی اغلب بهتر از استفاده از هر دارو به شکل منفرد و به تنهایی کار میکند. رژیمهای شیمی درمانی که بیشتر به عنوان اولین روش درمان سرطان بیضه استفاده میشود عبارتند از:
- BEP (یا PEB): بلئومایسین، اتوپوزید و سیس پلاتین
- EP: اتوپوزید و سیس پلاتین
- VIP: VP-16 (اتوپوزید) یا وینبلاستین به همراه ایفوسفامید و سیس پلاتین
برخی از پزشکان از برنامههای فشرده تری برای بیماران مبتلا به بیماریهای پرخطر استفاده میکنند و ممکن است ترکیب متفاوتی از داروهای شیمی درمانی یا حتی پیوند سلولهای بنیادی را پیشنهاد دهند.
عوارض جانبی احتمالی شیمی درمانی
داروهای شیمی درمانی به سلولهایی که به سرعت در حال تقسیم هستند حمله میکنند، به همین دلیل است که آنها علیه سلولهای سرطانی عملکرد دارند اما سایر سلولهای بدن، مانند سلولهای مغز استخوان (جایی که سلولهای خونی جدید ساخته میشوند)، پوشش داخلی دهان و روده و فولیکولهای مو نیز به سرعت تقسیم میشوند. این سلولها همچنین احتمالاً تحت تأثیر شیمی درمانی قرار میگیرند که میتواند منجر به عوارض جانبی خاصی شود.
عوارض جانبی شیمی درمانی به نوع و دوز داروهای مورد استفاده و مدت زمان تجویز آنها بستگی دارد. این عوارض جانبی میتواند شامل موارد زیر باشد:
- ریزش مو
- زخمهای دهانی
- از دست دادن اشتها
- تهوع و استفراغ
- اسهال
- افزایش احتمال عفونت (به دلیل داشتن گلبولهای سفید بسیار کم)
- کبودی یا خونریزی آسان (به دلیل داشتن تعداد بسیار کم پلاکت خون)
- خستگی (خستگی شدید، اغلب به دلیل داشتن گلبولهای قرمز بسیار کم)
برخی از داروهای مورد استفاده برای درمان سرطان بیضه میتوانند عوارض جانبی دیگری نیز داشته باشند. مثلا:
- سیس پلاتین و ایفوسفامید میتوانند باعث آسیب کلیه شوند. این عارضه را میتوان با دادن مایعات زیاد (معمولاً داخل ورید – IV) قبل و بعد از تجویز این داروها کاهش داد.
- سیس پلاتین، اتوپوزید، پاکلیتاکسل و وینبلاستین میتوانند به اعصاب آسیب بزنند (معروف به نوروپاتی یا neuropathy). این میتواند منجر به بی حسی یا سوزن سوزن شدن دستها و پاها و حساسیت به سرما یا گرما شود. در بیشتر موارد، پس از قطع دوره درمانی، این وضعیت بهتر میشود اما ممکن است در برخی افراد برای مدت طولانی ادامه داشته باشد.
- سیس پلاتین همچنین میتواند باعث از دست دادن شنوایی شود (به نام سمیت گوش یا ototoxicity)
- بلئومایسین میتواند به ریهها آسیب برساند و باعث تنگی نفس و ایجاد مشکل در فعالیت بدنی شود.
- ایفوسفامید میتواند باعث خونریزی مثانه شود (به نام سیستیت هموراژیک یا hemorrhagic cystitis). برای جلوگیری از این امر به بیمار مایعات فراوان داده میشود و داروی مسنا (mesna) همراه با ایفوسفامید تجویز میشود.

اکثر عوارض جانبی کوتاه مدت هستند و پس از پایان روند درمان و گذشت زمان از بین میروند اما برخی از آنها میتوانند مدت طولانی باقی بمانند و هرگز به طور کامل از بین نخواهند رفت. در مورد هر گونه عوارض جانبی یا تغییراتی که در حین انجام شیمی درمانی متوجه آن میشوید با تیم درمانی خود صحبت کنید تا بتوانید دوره درمان فوری این حالات و شرایط را دریافت کنید. اغلب راههایی برای پیشگیری یا کاهش عوارض جانبی وجود دارد. به عنوان مثال، داروهایی برای کمک به پیشگیری یا کاهش تهوع و استفراغ وجود دارد.
در برخی موارد، ممکن است لازم باشد دوز داروهای شیمی درمانی کاهش یابد یا روند درمان باید به تعویق بیفتد یا متوقف شود تا از بدتر شدن عوارض جانبی جلوگیری شود.
برخی از داروهای مورد استفاده برای درمان سرطان بیضه میتوانند عوارض جانبی طولانی مدت ایجاد کنند. این موارد شامل عوارضی است که قبلاً ذکر شد، مانند کاهش شنوایی و آسیب کلیه یا ریه. ایجاد سرطان دوم (مانند لوسمی) یک عارضه جانبی بسیار جدی اما نادر شیمی درمانی است که در کمتر از 1 درصد از بیماران مبتلا به سرطان بیضه که تحت درمان با شیمی درمانی قرار گرفته اند، رخ میدهد.
به نظر میرسد افرادی که شیمی درمانی برای سرطان بیضه داشته اند در آینده در معرض خطر بیشتری برای ابتلا به مشکلات قلبی هستند. چندین مطالعه همچنین نشان داده اند که شیمی درمانی گاهی اوقات میتواند باعث افزایش کلسترول خون در طول زمان شود که ممکن است بعداً نیاز به درمان داشته باشد.
شیمی درمانی با دوز بالا و پیوند سلولهای بنیادی برای سرطان بیضه
به طور کلی، سرطانهای بیضه به خوبی به شیمی درمانی (chemo) پاسخ میدهند، اما همه آنها درمان نمیشوند. اگرچه دوزهای بالاتر شیمی درمانی ممکن است بهتر عمل کند اما تجویز نمیشوند زیرا میتوانند به شدت به مغز استخوان آسیب بزنند، جایی که سلولهای خونی جدید تشکیل میشوند. این آسیب میتواند منجر به عفونتهای تهدید کننده زندگی، خونریزی و بروز سایر مشکلات به دلیل تعداد کم سلولهای خونی شود.
اما پیوند سلولهای بنیادی به پزشکان اجازه میدهد از دوزهای بالاتر شیمی درمانی استفاده کنند. سلولهای بنیادی قبلا از مغز استخوان گرفته میشد اما در حال حاضر این کار کمتر انجام میشود. در هفتههای قبل از درمان، دستگاه مخصوصی سلولهای بنیادی خونساز را از جریان خون بیمار جمع آوری میکند. این سلولها منجمد و ذخیره میشوند.
سپس بیمار دوزهای بالایی از شیمی درمانی را دریافت میکند. پس از شیمی درمانی، بیمار دوباره سلولهای بنیادی خود را به دست میآورد. این کار پیوند (transplant) نامیده میشود اما شامل جراحی نیست – سلولها مانند تزریق خون به داخل ورید تزریق میشوند. سلولهای بنیادی در مغز استخوان مستقر میشوند و طی چند هفته آینده شروع به ساخت سلولهای خونی جدید میکنند.
پیوند سلولهای بنیادی اغلب برای درمان سرطانهای بیضه که پس از درمان با شیمی درمانی عود کرده اند، استفاده میشود. مطالعات کنونی به دنبال این هستند که آیا پیوند سلولهای بنیادی ممکن است به عنوان بخشی از اولین دوره درمانی برای برخی از بیماران مبتلا به سرطان سلولهای زایای پیشرفته ارزشمند باشد.
پیوند سلولهای بنیادی یک روش درمانی پیچیده است که به دلیل استفاده از دوزهای بالای شیمی درمانی میتواند عوارض جانبی تهدید کننده زندگی ایجاد کند. مطمئن شوید که مزایا و خطرات احتمالی را درک کرده اید. اگر پزشکان فکر میکنند که شما ممکن است از پیوند سود ببرید، این عمل باید در بیمارستانی انجام شود که کارکنان آن در مورد این جراحی و مدیریت مراحل بهبودی تجربه دارند.
پیوند سلولهای بنیادی گاهی نیاز به بستری طولانی مدت در بیمارستان دارد و ممکن است هزینه زیادی داشته باشد. حتی اگر بیمه شما پیوند را پوشش دهد، هزینههای مشترک یا سایر هزینههای شما میتواند مبلغ زیادی را به همراه داشته باشد. قبل از تصمیم گیری در مورد انجام پیوند، مهم است که بدانید بیمه گر شما چه چیزی را پوشش میدهد تا ایده ای از مقدار آنچه که ممکن است مجبور به پرداخت آن باشید، داشته باشید.
گزینههای درمانی برای سرطان بیضه، بر اساس نوع و مرحله
درمان سرطان بیضه عمدتاً بر اساس نوع و مرحله سرطان است. در میان مراحل مختلف تومورهای سلول زایا، سمینومای خالص به یک طریق درمان میشوند و تومورهای غیر سمینوم و تومورهای سلول زایای مختلط به روشی دیگر درمان میشوند.
کارسینوم درجا (مرحله 0) تومورهای بیضه
در این مرحله، سرطان به خارج از بیضه گسترش نیافته است و سطوح نشانگر تومور (مانند HCG و AFP) افزایش نمییابد.
اگر CIS پس از برداشتن بیضه توسط جراحی تشخیص داده شود، به روش درمانی دیگری نیاز نیست. اگر CIS بعد از بیوپسی بیضه (مانند مشکلات باروری) پیدا شود، پزشک ممکن است توصیه کند که این نوع فوراً درمان نشود. درعوض، ممکن است با معاینات فیزیکی مکرر، سونوگرافی بیضه و آزمایش خون سطوح نشانگر تومور به دقت مشاهده شود. تا زمانی که هیچ نشانه ای از رشد یا تبدیل CIS به سرطان مهاجم وجود نداشته باشد، ممکن است نیازی به درمان نباشد. اگر CIS درمان شود، معمولاً روش درمانی مورد استفاده جراحی (برای برداشتن بیضه) یا پرتو درمانی بیضه است.
اگر سطح نشانگر تومور بالا باشد، سرطان واقعاً در مرحله 0 نیست – حتی زمانی که فقط CIS در بیضه یافت میشود و هیچ نشانه ای از گسترش سرطان وجود ندارد. در این مورد، روش درمان، درمانهای مورد استفاده برای سرطانهای مرحله IS است. (مطالب زیر را ببینید.)
سمینومها (Seminomas)
مرحله اول سمینوما
این سرطانها تقریباً در همه بیماران قابل درمان هستند. جراحی ابتدا برای برداشتن بیضه و طناب اسپرماتیک انجام میشود (به نام ارکیکتومی اینگوینال رادیکال). پس از جراحی، اغلب چندین گزینه درمانی وجود دارد:
مشاهده دقیق (نظارت): اگر سرطان به خارج از بیضه گسترش نیافته باشد، برنامه ای که اکثر متخصصان آن را ترجیح میدهند نظارت دقیق تا 10 سال است. این دوره به این معنی است که در سال اول هر 3 تا 6 ماه یکبار و یا در فواصل کمتر بعد از آن معاینه فیزیکی و آزمایش خون انجام دهید. آزمایشهای تصویربرداری (سی تی اسکن و گاهی عکس قفسه سینه) هر 3 ماه به مدت 6 ماه و سپس یک یا دو بار در سال انجام میشود.
اگر این آزمایشات هیچ علامتی مبنی بر گسترش سرطان به خارج از بیضه پیدا نکرد، به روش درمانی دیگری نیاز نیست. اگر سرطان گسترش یافته باشد، ممکن است از دورههای درمانی مانند پرتو درمانی یا شیمی درمانی استفاده شود.
سرطان در حدود 15 تا 20 درصد از بیماران عود میکند، اغلب به صورت سرایت به غدد لنفاوی اما اگر اینطور شود، پرتو درمانی یا شیمی درمانی معمولاً میتواند سرطان را درمان کند.
پرتو درمانی (Radiation therapy): پرتو درمانی با هدف غدد لنفاوی پاراآئورت (para-aortic lymph nodes) گزینه دیگری است. این گرهها در پشت شکم، اطراف رگ خونی بزرگی به نام آئورت قرار دارند. از آنجایی که سلولهای سمینوما به تابش بسیار حساس هستند، میتوان در این روش از دوزهای پایین استفاده کرد. حدود 10 تا 15 جلسه درمانی در طی 2 تا 3 هفته انجام میشود.
شیمی درمانی (Chemotherapy): گزینه ای که به خوبی پرتو درمانی عمل میکند، دریافت 1 یا 2 سیکل شیمی درمانی با داروی کربوپلاتین پس از جراحی است. بسیاری از متخصصان شیمی درمانی را به پرتو درمانی ترجیح میدهند زیرا به نظر میرسد تحمل آن آسان تر است.
مرحله IS سمینوم
در این مرحله، پس از برداشتن بیضه حاوی سمینوم، سطح یک یا چند نشانگر تومور همچنان بالاست. این نوع بسیار نادر است و با شیمی درمانی قابل درمان میباشد.
مرحله IIA سمینوم
پرتو درمانی: پس از جراحی برای برداشتن بیضه (ارکیکتومی رادیکال اینگوینال)، یکی از گزینههای درمانی پرتو درمانی به غدد لنفاوی خلفی (retroperitoneal lymph nodes) است. این غدد لنفاوی در پشت شکم قرار دارند. معمولاً به سمینومای مرحله دوم دوزهای بالاتری نسبت به سمینومای مرحله I داده میشود.
شیمی درمانی: گزینه دیگر شیمی درمانی است، با 4 چرخه EP (اتوپوزید و سیس پلاتین) یا 3 چرخه BEP (بلئومایسین، اتوپوزید و سیس پلاتین). سپس پزشک به دقت (هر 3 تا 6 ماه) علائم بازگشت سرطان را مشاهده میکند.
سمینومای مرحله IIB
این سمینومها برای ایجاد غدد لنفاوی بزرگتر یا به بسیاری از غدد لنفاوی مختلف گسترش یافته اند.
شیمی درمانی: این روش درمانی معمولاً ترجیح داده میشود. این روش معمولاً شامل یا 4 چرخه EP (اتوپوزید و سیس پلاتین) یا 3 چرخه BEP (بلئومایسین، اتوپوزید و سیس پلاتین) است.
پرتو درمانی: اگر غدد لنفاوی در اثر گسترش سرطان بزرگ نشده باشند، ممکن است این روش یک گزینه به جای شیمی درمانی باشد.
مرحله IIC سمینوم
روند درمان معمولاً شیمی درمانی با 4 سیکل EP (اتوپوزید و سیس پلاتین) یا 3 یا 4 چرخه BEP (بلئومایسین، اتوپوزید و سیس پلاتین) است. گزینه دیگر ممکن است VIP (اتوپوزید، ایفوسفامید و سیس پلاتین) برای 4 دوره باشد. پرتو درمانی معمولاً برای مرحله IIC سمینوما استفاده نمیشود.
غیر سمینوما (Non-seminomas)
مرحله اول غیر سمینوما
تقریباً همه این سرطانها قابل درمان هستند اما درمان با سمینوما متفاوت است. همانند سمینوما، درمان اولیه جراحی برای برداشتن بیضه و تومور است (به نام رادیکال ارکیکتومی اینگوینال). انتخابهای درمانی دیگر به مرحله سرطان بستگی دارد.
انتخاب برای مرحله IA (T1)
- مشاهده دقیق (نظارت): نظارت بیشتر متخصصان ترجیح داده میشود اما مستلزم مراجعات زیادی به پزشک و انجام آزمایشهای مختلف است. یک برنامه معمولی ممکن است شامل بازدیدهای 2 ماهانه برای سال اول، با سی تی اسکن هر 4 تا 6 ماه، سپس هر 3 ماه برای سال دوم، با اسکن هر 6 تا 12 ماه باشد. هر چه که زمان بگذرد و مشکلی نداشته باشید، زمان بین بازدید پزشک و انجام آزمایشها طولانی تر میشود. اگر سرطان عود کند (relapse)، معمولاً در یک یا دو سال اول رخ میدهد. عودها معمولاً با شیمی درمانی درمان میشوند. حتی اگر تعداد بیشتری از سرطانها در بیماران تحت نظارت نسبت به تشریح غدد لنفاوی عود کنند اما میزان معالجات تقریباً یکسان است زیرا عودها معمولاً زود تشخیص داده میشوند.
- تشریح غدد لنفاوی خلفی صفاقی (RPLND یا Retroperitoneal lymph node dissection): برداشتن غدد لنفاوی پشت شکم مزیت داشتن سرعت درمان اولیه بالا اما معایب جراحی بزرگ با عوارض احتمالی آن، از جمله از دست دادن توانایی انزال را دارد. به طور معمول پس از RPLND، اگر سرطان در گرهها یافت شود، ممکن است شیمی درمانی توصیه شود.
- شیمی درمانی: به جای جراحی، پزشک ممکن است 1 دوره از رژیم BEP (بلئومایسین، اتوپوزید و سیس پلاتین) را پیشنهاد کند. این کار به کاهش خطر عود سرطان کمک میکند.
انتخاب برای مرحله IB (T2، T3 یا T4)
- تشریح غدد لنفاوی خلفی صفاقی (RPLND): این عمل جراحی برای برداشتن غدد لنفاوی پشت شکم استفاده میشود. اگر سرطان در غدد لنفاوی یافت شود، شیمی درمانی اغلب بسته به تعداد غدد سرطانی در آنها توصیه میشود. (مطالب زیر را ببینید.)
- شیمی درمانی: به جای جراحی، پزشک ممکن است 1 دوره از رژیم BEP (بلئومایسین، اتوپوزید و سیس پلاتین) را توصیه کند. این کار میتواند به کاهش خطر بازگشت سرطان کمک کند. اگر بعد از جراحی سرطان در غدد لنفاوی یافت شد، بسته به تعداد غدد سرطانی ممکن است 2 تا 4 سیکل BEP یا EP (اتوپوزید و سیس پلاتین) داده شود. این کار میزان درمان بالایی را به همراه دارد اما میتواند عوارض جانبی (که اغلب کوتاه مدت هستند) نیز داشته باشد.
- مشاهده دقیق (نظارت): این امر مستلزم مراجعه مکرر به پزشک و انجام آزمایشات برای چندین سال است. این کار ممکن است گزینه ای برای برخی از تومورهای T2 باشد که به رگهای خونی نرسیده اند.
مرحله غیر سمینوما است:
اگر سطوح نشانگر تومور شما (مانند AFP یا HCG) حتی پس از برداشتن سرطان همچنان بالا است اما سی تی اسکن تومور را نشان نمیدهد، معمولاً شیمی درمانی توصیه میشود. این روند ممکن است شامل 3 چرخه BEP (بلئومایسین، اتوپوزید و سیس پلاتین) یا 4 چرخه EP (اتوپوزید و سیس پلاتین) باشد.
مرحله دوم غیر سمینوما
جراحی ابتدا برای برداشتن بیضه و طناب اسپرماتیک انجام میشود (به نام ارکیکتومی اینگوینال رادیکال). پس از جراحی، انتخابهای درمانی به جزئیات سرطان بستگی دارد.
مرحله IIA غیر سمینوما
روش درمان بستگی به سطوح نشانگر تومور پس از جراحی و میزان انتشار به غدد لنفاوی خلفی دارد. این غدد لنفاوی در پشت شکم قرار دارند.
اگر سطح نشانگر تومور طبیعی باشد، 2 گزینه اصلی وجود دارد:
- تشریح غدد لنفاوی خلفی صفاقی (RPLND): این عمل جراحی برای برداشتن غدد لنفاوی در پشت شکم است. اگر غدد لنفاوی برداشته شده حاوی سرطان باشند، ممکن است شیمی درمانی (معمولاً برای 2 سیکل) انجام شود. اگر سرطانی در گرهها وجود نداشته باشد، پزشک علائم بازگشت سرطان را به دقت بررسی میکند.
- شیمی درمانی: این روش شامل 4 چرخه EP (اتوپوزید و سیس پلاتین) یا 3 چرخه BEP (بلئومایسین، اتوپوزید و سیس پلاتین) است. اگر علائمی وجود داشته باشد که نشان دهد سرطان هنوز وجود دارد، ممکن است بعد از این کار جراحی انجام شود.
اگر نشانگرهای تومور پس از جراحی اولیه همچنان بالاتر از حد طبیعی باشد، درمان معمولاً با شیمی درمانی، همان طور که در بالا ذکر شد (EP یا BEP) انجام میشود.
مرحله IIB غیر سمینوما
روند درمان بستگی به سطوح نشانگر تومور پس از جراحی و میزان انتشار به غدد لنفاوی پشت شکم دارد. اینها غدد لنفاوی خلفی صفاقی نامیده میشوند.
اگر سطح نشانگر تومور طبیعی باشد، گزینههای پیش رو عبارتند از:
- شیمی درمانی: ممکن است از 4 سیکل EP (اتوپوزید و سیس پلاتین) یا 3 سیکل BEP (بلئومایسین، اتوپوزید و سیس پلاتین) استفاده شود. در صورت بازگشت تومور مارکر به حالت طبیعی، ممکن است جراحی برای خارج کردن تمام گرههای بزرگ شده انجام شود.
- تشریح غدد لنفاوی خلفی صفاقی (RPLND): در موارد معدودی که سرطان فقط به این غدد لنفاوی گسترش یافته است، ممکن است جراحی برای خارج کردن آنها انجام شود. ممکن است پس از جراحی شیمی درمانی داده شود.
اگر نشانگرهای تومور پس از جراحی اولیه همچنان بالاتر از حد طبیعی باشد، درمان معمولاً با شیمی درمانی، همان طور که در بالا ذکر شد (EP یا BEP) انجام میشود.
مرحله سوم سمینوم و غیر سمینوم
حتی با وجود اینکه سرطانهای مرحله سوم تا زمان پیدا شدن گسترش یافته اند، اکثر آنها هنوز قابل درمان هستند.
هر دو مرحله سوم سمینوم و غیر سمینوم، با ارکیکتومی اینگوینال رادیکال و به دنبال آن دریافت شیمی درمانی درمان میشوند. بسته به گروه خطری که سرطان در آن قرار میگیرد، این شیمی درمانی ممکن است با موارد زیر انجام شود:
- EP (اتوپوزید و سیس پلاتین) برای 4 سیکل
- BEP (بلئومایسین، اتوپوزید و سیس پلاتین) برای 3 یا 4 چرخه
- VIP (اتوپوزید، ایفوسفامید و سیس پلاتین) برای 4 سیکل
اگر شک زیادی وجود داشته باشد که سرطان ممکن است یک کوریوکارسینوم بیضه باشد، شیمی درمانی ممکن است بدون بیوپسی یا جراحی برای برداشتن بیضه شروع شود.
اگر سرطان به مغز سرایت کرده باشد، جراحی (اگر فقط 1 یا 2 تومور در مغز وجود دارد)، پرتو درمانی با هدف مغز یا هر دو روش ممکن است استفاده شود. اگر تومورهای مغز خونریزی ندارند یا علائمی را ایجاد نمیکنند، برخی از پزشکان ممکن است ابتدا شیمی درمانی را شروع کنند.
پس از اتمام شیمی درمانی، پزشک به دنبال بافت سرطانی باقیمانده میگردد. اگر اسکنها و سطوح نشانگر تومور طبیعی باشد، ممکن است نیازی به دریافت دوره درمانی بیشتر نباشد.
گاهی اوقات ممکن است چند تومور پس از گذشت دوره درمان باقی بماند. این تومورها اغلب در ریه یا غدد لنفاوی خلفی صفاقی هستند. دوره درمانی بیشتر در این مرحله به نوع سرطان بستگی دارد:
- سمینوم مرحله III که هنوز بعد از شیمی درمانی وجود دارد یا در اسکن PET “روشن” نمیشود، با سی تی اسکن مشاهده میشود تا بررسی شود که آیا رشد میکند یا خیر. اگر چنین شد، به دوره درمانی بیشتری نیاز است. اگر تومورها در اسکن PET روشن شوند، ممکن است سرطانی باشند و درمان لازم است. دوره درمانی ممکن است جراحی (مانند تشریح غدد لنفاوی خلف صفاقی) یا شیمی درمانی (با استفاده از ترکیب متفاوتی از داروها) باشد.
- تومور غیر سمینومای مرحله III که پس از دوره درمان باقی میماند معمولاً با جراحی برداشته میشود که ممکن است منجر به معالجه کامل شود. اگر سرطان در تومورهای برداشته شده یافت شود، ممکن است به شیمی درمانی بیشتری (شاید با داروهای مختلف) نیاز داشته باشید. پس از این، ممکن است جراحی برای خارج کردن تومورهای باقی مانده انجام شود.
اگر سرطان به شیمی درمانی مقاوم باشد یا به بسیاری از اندامها گسترش یافته باشد، ممکن است دوزهای معمول شیمی درمانی همیشه کافی نباشد. پزشک ممکن است شیمی درمانی با دوز بالا را به دنبال پیوند سلولهای بنیادی توصیه کند. ثبت نام در کارآزمایی بالینی یک رژیم شیمی درمانی جدیدتر ممکن است گزینه خوب دیگری باشد.
سرطان عود کننده بیضه (Recurrent testicular cancer)
اگر سرطان با دریافت دورههای درمانی برطرف شود و سپس عود کند، گفته میشود که سرطان عود کرده است. اگر این اتفاق بیفتد، معمولاً در 2 سال اول پس از درمان رخ میدهد. به طور کلی، اگر سرطان عود کرد، احتمالاً بهتر است قبل از شروع روند درمان، نظر دومی را از یک مرکز با تجربه گسترده در درمان سرطان عود کننده بیضه دریافت کنید.
درمان تومورهای سلول زایای عود کننده به روش درمانی اولیه و محل عود سرطان بستگی دارد. در صورتی که عود سرطانی که در غدد لنفاوی خلف صفاقی عود میکند کم باشد و تنها درمان جراحی که قبلا انجام شده است، ارکیکتومی بوده باشد، میتوان آن را با جراحی برای برداشتن گرهها (RPLND) درمان کرد. بسته به نتایج جراحی، ممکن است شیمی درمانی نیز توصیه شود.
اگر به نظر میرسد که سرطان در بسیاری از غدد لنفاوی خلف صفاقی عود کرده است یا اگر سرطان به جای دیگری بازگشته است، معمولاً شیمی درمانی توصیه میشود. ممکن است به دنبال آن جراحی نیز انجام شود.
اگر سرطان مرد بعد از شیمی درمانی عود کند یا اگر روند درمان دیگر مؤثر نباشد، فرد با رژیمهای شیمی درمانی متفاوتی درمان میشود که معمولاً شامل ایفوسفامید، سیسپلاتین و اتوپوزید، پاکلیتاکسل یا وینبلاستین است.
درمان سرطان بیضه که بعد از شیمی درمانی عود کرده است، همیشه آنطور که پزشکان میخواهند مؤثر نیست، بنابراین برخی از پزشکان ممکن است شیمی درمانی با دوز بالا و سپس پیوند سلولهای بنیادی را توصیه کنند. این ممکن است برای برخی از مردان مبتلا به بیماری عود کننده، به جای شیمی درمانی استاندارد، گزینه بهتری باشد. شرکت در آزمایشهای بالینی روشهای درمانی جدیدتر نیز ممکن است گزینههای خوبی باشند.
تومورهای سلول سرتولی و لیدیگ
به طور معمول، ارکیکتومی اینگوینال رادیکال درمان تومورهای سلول سرتولی و سلول لیدیگ است. پرتو درمانی و شیمی درمانی به طور کلی برای این انواع نادر تومورهای بیضه کار نمیکنند. اگر پزشک مشکوک باشد که تومور به خارج از بیضه گسترش یافته است، غدد لنفاوی خلفی صفاقی ممکن است با جراحی برداشته شوند.
بیشتر بخوانید:
- سرطان پانکراس (Pancreatic Cancer) چیست؟
- سرطان مری (Esophagus Cancer) چیست؟
- سرطان حنجره و هیپوفارنکس (Hypopharyngeal & Laryngeal Cancers) چیست؟
مترجم: فاطمه فریادرس




معنایmeixed seminomaدر سرطان بیضه
معنای “Mixed Seminoma” در زمینه سرطان بیضه به وجود توموری اشاره دارد که از اجزای مختلف بافتی تشکیل شده است، شامل سمینوما و دیگر انواع تومورهای جرمسلولی غیرسمینوما (non-seminoma). این نوع سرطان بیضه به عنوان تومورهای جرمسلولی مختلط (Mixed Germ Cell Tumor) نیز شناخته میشود و میتواند شامل اجزایی مانند امبریونال کارسینوما، یوکسک ساک تومور، کوریوکارسینوما، و تراتوما باشد.
با سلام اخیرا متوجه توده ای اندازه گردو در زیری ترین قسمت کیسه بیضه شده ام و توده کوچکتری هم بغل این توده هست که به خود بیضه وصل نیستنددر وسط هم هستند نه میشه گفت زیر بیضه چپه یا زیر بیضه راست خیلی هم درد دارد و نمیدونم مال کدومشون هست چکنم؟ با تشکر
به پزشک مراجعه کنید